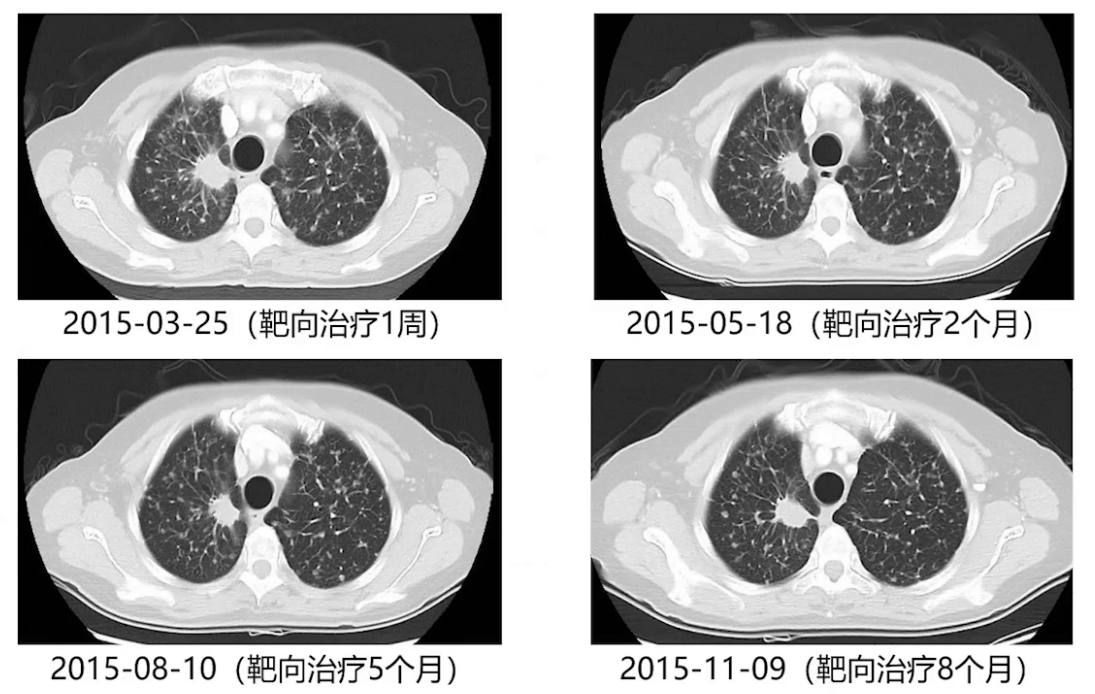
图片6.png

查看更多
密码过期或已经不安全,请修改密码
修改密码
壹生身份认证协议书
同意
拒绝
同意
拒绝
同意
不同意并跳过
64岁女性,主诉咳嗽、咳痰半年余,加重伴气促2周。
2014年10月外院胸部CT显示右肺上叶肿物直径约2cm,双肺多发结节,考虑转移;PET-CT提示右肺上叶高代谢肿物,双肺多发结节部分FDG轻度摄取,左肺门纵隔及左锁骨上淋巴结考虑转移;气管镜检查见右肺中叶内侧段支气管新生物阻塞,但活检未取到肿瘤组织。患者初始选择中药治疗,症状有所缓解。
2015年3月,患者症状突然加重,外院复查胸部CT示右肺上叶肿物直径达3.1cm,双肺结节及纵隔多发淋巴结肿大,腹部CT提示右侧肾上腺肿物,考虑髓样脂肪瘤可能性大,全身骨扫描未见转移征象。
1998年因“子宫肌瘤”行子宫切除术,余无特殊。
血浆EGFR基因检测未检测到突变。
2024.11.2 外院胸部CT:

2025.3.2 外院胸部CT:

1、2015.3.12局麻下行左锁骨上淋巴结活检术
术后病理提示腺癌转移,ALK基因检测阴性,基因检测提示EGFR 21外显子缺失突变,确诊右肺上叶腺癌,临床分期为T4N3M1A Ⅳ期。
2、靶向治疗起始与效果
2015年3月18日患者开始口服阿来替尼进行靶向治疗,1周后一般状况明显改善,可独立行走,复查胸部CT示双肺弥漫结节有所缓解;2个月后复查,双肺弥漫结节仍在缓解,但右肺上叶肿物变化不明显,处于稳定状态。

3、首次手术干预
2015年11月完善全身评估后,12月3日行胸腔镜下右肺上叶切除术,术后病理见少量腺癌残留(约10%),瘤床内肿瘤大部分变性坏死、间质纤维化及泡沫样组织细胞浸润。术后继续厄洛替尼靶向治疗。

4、靶向药物调整
术后3个月、6个月及9个月复查,双肺结节逐渐增大,考虑厄洛替尼耐药,2016年10月改服奥西替尼。两个月后影像复查,双肺增大的结节再次缓解。此后每2-3个月复查胸部增强CT,每半年进行一次全身检查。





5、第二次手术干预
2018年9月发现左肺上叶新增结节并逐渐增大,2021年1月全身评估后,考虑患者处于寡进展状态,2月行胸腔镜下左肺上叶楔形切除术,切除增大结节。术后病理提示肺组织中可见中低分化腺癌,浸润肿瘤最大径1.2cm,送检NGS检测提示EGFR exon19缺失突变、EGFR exon20的T790M突变及MET基因扩增。术后继续奥西替尼靶向治疗。


6、联合靶向治疗
2022年5月开始左肺结节逐渐增大,2023年7月复查时结节明显增大,PET-CT检查全身评估后,经多学科讨论,因既往NGS检测提示MET扩增,考虑口服塞沃替尼靶向治疗后复查再评估是否放疗,8月开始奥西替尼联合塞沃替尼治疗,1个月后胸部CT复查,左肺增大的结节明显缩小。因治疗药物有明显消化道不良反应,9月改用氟美替尼联合塞沃替尼治疗,患者目前维持治疗,一般情况良好。



查看更多
专家点评
本病例展示了一例晚期肺癌患者在长达十年的诊疗过程中,外科手术三次关键性介入所发挥的独特且重要的作用,充分体现了外科在晚期肺癌多学科综合治疗中的价值。
首次外科介入:快速确诊,扭转病程。患者在确诊初期已处于广泛转移的紧急状态。外科通过锁骨上淋巴结活检,在局部麻醉下迅速获取充足组织,并在1小时内获得快速冰冻病理诊断。此举为立即送检基因检测、在一周内明确分子分型并启动精准靶向治疗奠定了基础,使患者病情得以迅速扭转。
第二次外科介入:清除寡残留,延长药物获益。患者在口服一代EGFR-TKI近一年后,全身转移灶控制良好,但右肺原发灶成为突出的“寡残留”病灶。此时,外科实施楔形切除术,定点清除了该残留病灶。此次干预使患者一线靶向治疗的有效持续时间显著超过了该类药物平均1-1.5年的耐药期,患者从中明确获益。
第三次外科介入:处理寡进展并明确耐药机制。患者换用三代EGFR-TKI后再次进展,表现为左肺“寡进展”。外科第三次手术切除进展病灶,兼具治疗与诊断双重目的,一方面控制了局部进展,使患者能继续从三代TKI中获益;另一方面,利用获取的充足组织进行基因检测,成功揭示了耐药机制为MET扩增。这一关键发现直接指导了后续联合MET抑制剂的精准治疗,再次取得良好疗效。
总结而言,该患者历经9年长生存,三次外科手术在不同阶段扮演了至关重要的角色:1. 诊断先锋,在急症下快速获取组织,为精准治疗铺路;2.治疗利器,在全身治疗有效时,手术清除寡残留/寡进展病灶,巩固并延长全身治疗效果;3.科研窗口,在耐药节点提供高质量组织标本,揭示耐药机制以指导后续精准治疗。